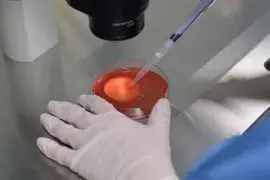

Préserver sa fertilité
Dans certaines maladies, le traitement peut agir sur la capacité biologique à avoir des enfants. Vous pouvez alors recourir à une « préservation de la fertilité ».

La préservation de la fertilité est un traitement préventif, qu’on réalisera avant le traitement de la maladie, afin de préserver – du point de vue biologique – vos possibilités d’avoir des enfants. Cependant, quelles que soient les techniques utilisées, les mesures de préservation de la fertilité ne permettent actuellement pas de garantir une grossesse.
L’AP-HP est le 1er centre de préservation de la fertilité en Ile-de-France. Ses 4 sites, Cochin – Paris 14ème, Jean Verdier (93), Tenon – Paris 20ème et Antoine-Béclère/Bicêtre (92), proposent toutes les techniques actuellement disponibles de préservation, pour les femmes, les hommes et les enfants.
Qui est concerné ?
Les adultes en âge de procréer, femmes (< 40 ans) ou hommes, tout comme les enfants et les adolescents, peuvent bénéficier de mesures de préservation de leur fertilité, dès qu’ils sont amenés à recevoir un traitement toxique pour la fertilité. La toxicité varie selon le type de maladie, les doses de traitements et l’âge du patient ou de la patiente.
Il s’agit notamment de certains traitements anti-cancéreux (chimiothérapie, radiothérapie ou chirurgie), ou nécessaires à traiter des pathologies non malignes telles que la drépanocytose, le lupus ou la polyarthrite rhumatoïde, etc.
Rappelons que la congélation d’ovocytes dans le simple but de repousser l’âge de la maternité sans avoir à subir la baisse de la fertilité lié à l’âge est actuellement interdite en France.
En savoir plus sur la réglementation relative à la préservation de la fertilité
Comment se passe la prise en charge ?
Le médecin qui prescrit un traitement présentant un risque pour votre fertilité est tenu de vous informer sur :
- la toxicité du traitement en ce qui concerne la fertilité ;
- les possibilités de préservation de la fertilité et l’absence de garantie de grossesse ;
- les techniques alternatives d’accès à la parentalité (don d’ovocytes ou de sperme, adoption) ;
- les méthodes contraceptives adaptées à la maladie.
Le médecin vous adresse ensuite à une consultation de préservation de la fertilité. Cette dernière est pluridisciplinaire : elle implique des médecins et biologistes de la reproduction, ainsi que des psychologues. Idéalement, elle se déroule avant tout traitement présentant des risques pour votre fertilité. Pour ne pas retarder vos traitements, dans les cas urgents, l’AP-HP s’engage à proposer une consultation de préservation de la fertilité en urgence, en moins de 48 heures.
La consultation déclenche le début du suivi, qui sera ensuite organisé avec vous de manière continue, selon votre situation médicale.
Chez les hommes comme chez les femmes, de même que chez les enfants et les adolescents, le principe de la préservation de la fertilité consiste à prélever puis conserver par le froid – on parle de « cryopréservation » - des éléments du corps qui pourront plus tard être utilisés lors d’un projet de parentalité.
Dans tous les cas, un suivi approprié est souhaitable même très longtemps après le traitement.
À voir aussi
Préserver sa fertilité
Les coulisses du service de Biologie de la reproduction - CECOS de l’hôpital Tenon, AP-HP